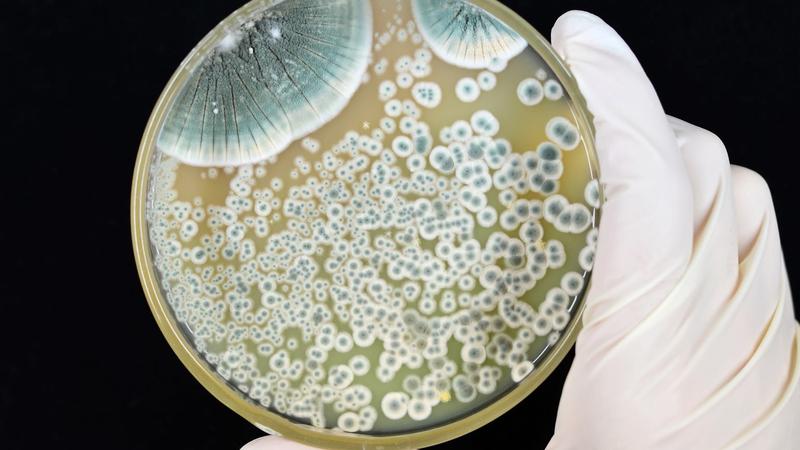
Bezpieczne stosowanie penicyliny

Okres laktacji staje się dla wielu matek wyjątkowym czasem, pełnym radości, ale takżwiążących się z pewnymi wątpliwościami dotyczącymi zdrowia dziecka oraz bezpieczeństwa stosowanych leków. Kiedy zachodzi potrzeba przyjmowania antybiotyków, takich jak penicylina, niezwykle istotne jest, aby wiedzieć, jak te leki wpływają na laktację oraz zdrowie noworodka. Na szczęście, penicyliny, w tym amoksycylina, zazwyczaj pozostają sprzymierzeńcami matek. Zgodnie z klasyfikacją doktora Hale’a, leki te zaliczają się do kategorii L1, co oznacza, że są bezpieczne do stosowania w trakcie karmienia piersią. Możesz spokojnie przystąpić do grona mam, których nie dręczą obawy o zdrowie ich maluszka, podczas gdy one same zmagają się z bakteriami.
- Penicylina i jej pochodne, takie jak amoksycylina, są klasyfikowane jako bezpieczne w trakcie karmienia piersią (kategoria L1 według dok. Hale’a).
- Penicylina przenika do mleka matki w minimalnych ilościach (mniej niż 0,95% dawki matki).
- Przyjmowanie leku najlepiej synchronizować z karmieniem (po karmieniu), aby zminimalizować ryzyko dla dziecka.
- Monitorowanie dziecka i zgłaszanie wszelkich niepokojących objawów lekarzowi jest kluczowe.
- Probiotyki mogą wspierać zdrową florę bakteryjną u noworodków podczas antybiotykoterapii.
- Należy być ostrożnym w przypadku innych leków, które mogą mieć negatywny wpływ na laktację lub zdrowie dziecka.
- Objawy reakcji alergicznych u dziecka mogą obejmować wysypkę, katar, kichanie i bóle brzuszka.
- W każdej sytuacji związanej z leczeniem warto konsultować się z lekarzem, aby zapewnić bezpieczeństwo matki i dziecka.
Niezwykle istotne pozostaje jednak, aby pamiętać, że penicylina w mleku matki występuje w minimalnych ilościach – stanowią one mniej niż 0,95% dawki przyjętej przez matkę. W sytuacji, gdy dziecko nie przejawia żadnych niepokojących objawów, można z pełnym przekonaniem kontynuować karmienie. Niemniej jednak, jak to w życiu bywa, istnieją wyjątki! Kiedy przyjmowanie leku wiąże się z ryzykiem, lekarz może zasugerować przerwę w laktacji. Ale spokojnie! Mimo że takie momenty mogą budzić stres, nie należy obawiać się o utratę laktacji – odciąganie pokarmu stanowi doskonałe rozwiązanie!
Bezpieczeństwo antybiotyków w laktacji
W trakcie antybiotykoterapii niezwykle ważne staje się stosowanie leków, które znajdują się w kategorii L1, co świadczy o ich niskim ryzyku. Penicylina jest doskonałym przykładem, ponieważ nie tylko jest bezpieczna, ale również odgrywa ważną rolę w pediatrii. Niestety, nie każda mama zdaje sobie sprawę, jak prowadzić taką kurację. Kluczowe pozostaje zsynchronizowanie czasu przyjmowania antybiotyku z karmieniem – najlepiej tuż po karmieniu, aby zminimalizować ewentualne przenikanie substancji czynnej do mleka na najwyższym poziomie. Ponadto, staranna obserwacja dziecka podczas antybiotykoterapii będzie niezmiernie ważna – wszelkie zmiany należy natychmiast zgłaszać lekarzowi. I pamiętaj: zdrowy tryb życia, odpowiednia karma oraz probiotyki stanowią Twoich najlepszych sprzymierzeńców!
Podsumowując, działanie penicyliny przynosi korzyści nie tylko matkom, ale także ich pociechom! Gdy lekarz decyduje o podaniu tego leku, warto mieć pewność, że przyniesie więcej korzyści niż szkód. Dlatego, drogie mamy – nie lękajcie się przyjmować bezpiecznych antybiotyków, takich jak penicylina, ponieważ zdrowie Was oraz Waszych maluszków stoi na pierwszym miejscu! A laktacja? Na pewno nie stanie się ofiarą, jeśli będziecie postępować według sprawdzonych zasad!
Zasady bezpiecznego stosowania penicyliny w trakcie karmienia: co mówią eksperci?
Stosowanie penicyliny w trakcie laktacji bywa tematem, który często wzbudza obawy wśród mam. Na szczęście, eksperci są jednomyślni – w większości przypadków nie ma powodów do niepokoju! Penicylina oraz jej pochodne, takie jak amoksycylina, klasyfikowane są w kategorii L1 według dr. Hale’a, co świadczy o ich bezpieczeństwie dla karmiących mam. Należy jednak pamiętać, że ulotka, która często bywa naszym najlepszym źródłem informacji, nie zawsze okazuje się wiarygodnym doradcą. Wiele z nich zawiera komunikat „nie stosować w trakcie laktacji”, co nie zawsze odzwierciedla rzeczywistość.
Czy penicylina to przyjaciel, czy wróg?
Zamiast obawiać się opisu działania leku, zalecamy konsultację z lekarzem, który z pewnością zrozumie Wasze wątpliwości i pomoże dobrać najlepszą terapię. Pomyślcie tylko, lekarz pełni rolę superbohatera w białym kitlu, który nigdy nie zostawia mamy samej w trudnych chwilach! Pamiętając o przyjmowaniu leku po karmieniu, można zminimalizować negatywny wpływ leku na maluszka. Prosta zasada brzmi: najpierw znika mleko, a potem wraca w pełnej krasie, podczas gdy penicylina działa, ratując zdrowie mamy!
Nie zapominajmy również o probiotykach! Antybiotyki, w tym penicylina, zwalczają bakterie, ale niszczą także te dobre, które dbają o nasz brzuch. Dlatego warto rozważyć dodanie do diety łyżki jogurtu lub suplementów probiotycznych, które wzmocnią florę jelitową. Dzięki nim życie będzie znacznie spokojniejsze zarówno dla mamy, jak i dziecka. Warto także zwrócić uwagę na zdrową dietę, bo witaminy i minerały wciąż są w modzie, a podczas antybiotykoterapii mogą okazać się niezwykle pomocne!
- Przykłady probiotyków, które warto rozważyć:
- Jogurt naturalny
- Suplementy probiotyczne w tabletkach
- Fermentowane produkty mleczne
Kiedy lepiej powiedzieć „nie”?
Chociaż penicylina ma swoją pewną pozycję w laktacyjnym leksykonie, warto pamiętać, że nie wszystkie leki są tak tolerancyjne. Nie ma sensu łudzić się, że wszystko jest tak bezpieczne jak mleko matki. W przypadku leków o wysokiej dawce, takich, które mogą kumulować się w organizmie, oraz tych, które mogą hamować laktację, należy zachować ostrożność. W takim przypadku konsultacja z lekarzem staje się kluczem do sukcesu! Choć odciągniętego mleka nie wykorzystamy, przynajmniej mamy pewność, że zdrowie mamy pozostaje na pierwszym miejscu, a maluch może spokojnie czekać na kolejne posiłki prosto z piersi!
Alternatywy dla penicyliny – czy można je stosować podczas karmienia piersią?
Okres karmienia piersią przynosi wiele radości, ale także wyzwań. Gdy w dodatku mama musi przyjmować leki, z pewnością staje przed pytaniem: „Czy to będzie bezpieczne dla mojego maluszka?”. W kontekście antybiotyków, penicyliny zajmują czołowe miejsce, jeśli chodzi o bezpieczeństwo stosowania w czasie laktacji. To prawda! Penicyliny działają jak prawdziwi bohaterowie w walce z infekcjami, a ich towarzyszką, amoksycyliną, można nazwać superbohaterką, której przyda się każdej karmiącej matce!
Co mówi nauka o penicylinach?
Pamiętaj, że według klasyfikacji doktora Hale’a penicyliny znajdują się w kategorii „bezpiecznych”. Te leki zwalczają bakterie, osiągając jednocześnie niewielkie stężenie w mleku matki, co przekłada się na znikomy wpływ na maluszka. Co więcej, badania pokazują, że mniej niż 0,5% dawki, która trafia do mamy, przenika do jej mleka! To tak mało, jak kropla w morzu, prawda? Dlatego w większości przypadków lekarze przepisują amoksycylinę bez obaw o zdrowie dzieci, co sprawia, że cieszy się ona dużym zaufaniem wśród pediatrów.
Jednak nie daj się zwieść! Nawet jeśli leki noszą miano superbohaterów, czasami mogą nie pasować do danej sytuacji. Dlatego niezwykle istotne jest, aby omawiać każdą decyzję dotyczącą leczenia z lekarzem. Warto rozpocząć przyjmowanie leków po karmieniu, aby minimalizować ewentualne ryzyko dla maluszka. A mówiąc o lekkim chłodzie po antybiotyku, nie zapomnij pomyśleć o probiotykach, które wspomagają odbudowę flory bakteryjnej w jelitach – one również mają kluczowe znaczenie w tej symfonii zdrowia!
Alternatywy i bezpieczeństwo
Choć penicyliny to bezpieczne opcje, czasami los potrafi nas zaskoczyć i lekarz może zaproponować inne antybiotyki, takie jak makrolidy. Antybiotyki, na przykład azytromycyna, zapewniają dość przyzwoite wyniki, ale również tutaj zasada pozostaje niezmienna: zawsze konsultuj się ze specjalistą. Kluczowym elementem przyjmowania jakiegokolwiek leku w czasie laktacji jest zasada „po karmieniu”, ponieważ zmniejsza to ryzyko przenikania substancji do mleka. Jeśli lekarz zasugeruje przerwę w karmieniu na kilka godzin – warto go posłuchać!
Podsumowując, podczas karmienia piersią można z pewnością stosować antybiotyki, ale aby uniknąć niepotrzebnych zmartwień, dobrze korzystać z dostępnych źródeł, jak Laktacyjny Leksykon Leków. A jeśli dany lek nie znajduje się w tych zestawieniach, lepiej zrezygnować z jego przyjmowania. Pamiętajmy, że nasze zdrowie jest ważne, ale zdrowie maluszka zawsze powinno mieć absolutny priorytet!
Znaki ostrzegawcze: jak rozpoznać ewentualne reakcje alergiczne u matki i dziecka?
Kiedy stajemy się mamami, świat nagle wypełnia się nowymi wyzwaniami. Umiejętność rozpoznawania reakcji alergicznych zarówno u nas, jak i u naszych maluszków ma kluczowe znaczenie. Chociaż karmienie piersią to wspaniałe doświadczenie, czasami nasza dieta lub leki, które przyjmujemy, mogą wywołać u dziecka niepokojące objawy. Aby uniknąć paniki za każdym razem, gdy dostrzeżemy coś nietypowego, warto znać znaki ostrzegawcze, które mogą wskazywać na to, że coś jest nie tak.
Reakcje alergiczne objawiają się na różne sposoby – najbardziej niepokojącym sygnałem wydaje się nagle pojawiająca wysypka na skórze dziecka, która przypomina, jakby mały Picasso urządził sobie malarską imprezę na delikatnej skórze. Ważne jest, aby zwrócić uwagę na dodatkowe objawy, takie jak swędzenie, czerwone plamy czy opuchlizna. Choć każdy z tych objawów nie zawsze oznacza alergię, w przypadku problemów z oddychaniem czy intensywnego płaczu u dziecka, natychmiast skontaktuj się z lekarzem!
Jakie są najczęstsze objawy alergii?

Alergie przybierają różne formy, dlatego należy pozostać czujnym. Do najczęściej występujących objawów należą katar, kichanie czy łzawienie, które mogą przypominać przeziębienie. Jeśli te objawy pojawiają się nagle i są silniejsze niż zwykle, warto umówić się na wizytę u lekarza. Nie można również zapominać o bólach brzuszka, wzdęciach czy problemach z wypróżnianiem – mogą one wskazywać na to, że maluch ma problem z jakimś składnikiem, który spożywasz. W przypadku, gdy mama przyjmuje leki, zaleca się sprawdzenie ich wpływu na organizm malucha, ponieważ nawet najprostsze lekarstwa potrafią wprowadzić zamieszanie w organizmie dziecka!
Oto lista najczęstszych objawów alergii, na które warto zwrócić uwagę:
- Katar nie ustępujący przez dłuższy czas
- Kichanie, szczególnie w kontakcie z alergenami
- Łzawienie oczu i ich swędzenie
- Wysypka skórna, szczególnie po spożyciu określonych pokarmów
- Bóle brzuszka i problemy z wypróżnianiem
Na koniec pamiętaj, że zdrowie maluszka stanowi nasz priorytet, lecz nie warto popadać w hipohondrię! W sytuacji, gdy zauważysz jakiekolwiek niepokojące objawy, zawsze zasięgaj porady specjalisty. Jako matki jesteśmy odważne jak lwy, ale czasami potrzebujemy wsparcia. Nie wahaj się więc zapytać swojego pediatrę o wszystko, co budzi Twoje wątpliwości. Kto wie, może jego odpowiedzi sprawią, że poczujesz się jak superbohaterka, zdolna stawić czoła wszystkim alergiom!
| Objaw | Opis |
|---|---|
| Katar nie ustępujący przez dłuższy czas | Może przypominać objawy przeziębienia, ale utrzymuje się dłużej. |
| Kichanie | Szczególnie w kontakcie z alergenami, może występować nagle. |
| Łzawienie oczu | Swędzenie oczu i ich łzawienie mogą wskazywać na reakcję alergiczną. |
| Wysypka skórna | Pojawia się szczególnie po spożyciu określonych pokarmów. |
| Bóle brzuszka | Problemy z wypróżnianiem oraz dolegliwości brzuszne mogą wskazywać na nietolerancję. |
Ciekawostką jest to, że niektóre dzieci mogą wykazywać alergie na substancje obecne w diecie matki nawet po kilku tygodniach regularnego karmienia piersią, co oznacza, że pokarmy, które jedzą mamy, mogą mieć długotrwały wpływ na zdrowie ich maluszków.
Pytania i odpowiedzi
Jakie są najważniejsze informacje o bezpieczeństwie stosowania penicyliny podczas karmienia piersią?
Penicylina, w tym amoksycylina, zaliczana jest do kategorii L1 według klasyfikacji doktora Hale’a, co oznacza, że jest bezpieczna dla karmiących mam. Leki te występują w mleku matki w minimalnych ilościach, co sprawia, że nie należy się obawiać o zdrowie maluszka w większości przypadków.
Co powinno się robić podczas przyjmowania penicyliny w kontekście karmienia?
Najlepiej przyjmować penicylinę tuż po karmieniu, aby zminimalizować przenikanie substancji czynnej do mleka. Dodatkowo, obserwacja dziecka podczas terapii antybiotykowej jest kluczowa, a wszelkie niepokojące objawy warto niezwłocznie zgłaszać lekarzowi.
Kiedy należy rozważyć przerwę w karmieniu podczas stosowania penicyliny?
W sytuacjach, gdy zastosowanie penicyliny wiąże się z ryzykiem, lekarz może zasugerować przerwę w laktacji. Jednak warto pamiętać, że odciąganie pokarmu może być skutecznym sposobem na zachowanie laktacji podczas leczenia.
Czy każda mama może bezpiecznie stosować penicylinę?
Mimo że penicylina jest generalnie bezpieczna, nie wszystkie leki w czasie laktacji są tak tolerowane. W przypadku stosowania antybiotyków o wysokiej dawce lub tych, które mogą hamować laktację, konsultacja z lekarzem jest kluczowa.
Jakie objawy mogą wskazywać na reakcje alergiczne u matki lub dziecka?
Należy obserwować objawy takie jak wysypka, swędzenie, katar, kichanie, a także problemy z oddychaniem. Jeśli zauważysz jakiekolwiek niepokojące symptomy, od razu skontaktuj się z lekarzem, aby uzyskać odpowiednią pomoc.
